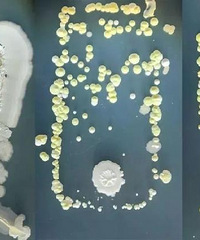
ֻҲ͹״壡

那些吃穿山甲的人怎么下得了口啊!
1个月前 收录

找资料的时候,看到了第一财经对穿山甲的专题报道,里面有一段描写,太残酷、也太让人难过了……―― 心理承受能力不太好的同学请谨慎点开的分割线 ――参与了这么多穿山甲解救,吴诗宝(国内穿山甲研究权威学者)最难忘的还是一对母子。2001年8月,某市林业公安局一个弥漫着腥臊味的小房间里,堆满尼龙网袋。里面是50多只走私的穿山甲。打开一只大袋子后,重重叠叠的
查看详情>>
阅读:5.8万回复:145
养老金准时到,千万莫要扎堆取
1个月前 收录

来源:重庆发布请广大离退休人员放心,重庆市社保经办机构仍然将按时足额发放您的养老待遇,我们倡导大家在家通过互联网PC客户端或智能手机APP客户端进行各项金融在线服务,比如,如需查询养老金到账信息,建议通过手机关注银行公众号进行查询,如需进行缴费、转账等,建议通过支付
查看详情>>
阅读:2027回复:6
10号开工的都是哪些行业?
1个月前 收录

我先来,金融行业,下周一开始上班,我们部门是轮流上班,一个人需要上班2天,这段时间也在家里办公,就是有点担心吃饭问题,只能自己带饭了。
查看详情>>
阅读:10.2万回复:171
有招聘求职需求的朋友,来这里看看
1个月前 收录

最近由于疫情的原因大家都呆在家里,不少朋友表示从未如此想过上班……以往春节后就迎来了职场的“金三银四”,现在由于特殊情况可能有所延后但这也不妨碍大家提前做好准备。有招聘、求职需求的朋友都来跟帖回复吧 请按格式跟帖,不要发水帖我要招聘:岗位:待遇:岗位要求:工作地
查看详情>>
阅读:6.0万回复:147
为什么现在基本没得超市卖子弟了?
1个月前 收录

子弟我小时候吃到现在,绝对比可比克,品客之流好吃,可比克一无是处主要优点就是便宜;品客主要优势就是品控好,但是薯片全都是薯片粉末机器成型,少了点味;乐视的麻辣味口味太重,其他味又优点寡淡;上好佳是唯一能和子弟拼一手的,但是上好佳吃多了优点腻,子弟没那么容易腻。之前还有在超市看到过子弟的身影,现在基本都没有了。我问了一些超市的他们都直接回答
查看详情>>
阅读:6.8万回复:229
你每天的微信步数是多少?都干嘛了
1个月前 收录

我的步数跟我的心跳一样平稳…每天大部分时候都呆在床上追剧,除了吃饭上厕所要出房门以外,就这样每天都在在700多步,比我想象中多
查看详情>>
阅读:7375回复:5
重庆医科大学成功研发检测试剂盒
1个月前 收录

日前,重庆医科大学联合博奥赛斯生物科技有限公司成功研发出了新型冠状病毒(2019-nCoV)化学发光免疫检测试剂盒。新型冠状病毒肺炎疫情爆发后,重庆医科大学承担了重庆市抗新型冠状病毒重点应急攻关“2019-nCoV免疫诊断试剂盒”研究项目。该项目由中华医学会微生物学与免疫学分会主任委员、重庆医科大学感染性疾病分子生物学教育部重点实验室执行主任黄爱龙教授领衔
查看详情>>
阅读:6445回复:16
新冠疑似患者隔离期间的心路历程
1个月前 收录

我觉得非常有必要来发一张帖子,我很少发帖的,语言组织能力也不强,就挨着说吧!先从怎么发生的说起吧:盼着春节期间有几天假期,平时也没有时间带娃出去旅游过,娃4岁多了出去体验一下吧 然后刚好广州的一个朋友正好也是春节期间要到处游玩一圈,计划的是去长沙、武汉、郑州,但
查看详情>>
阅读:11.0万回复:139
重庆同一天9名确诊患者治愈出院
1个月前 收录

华龙网-新重庆客户端2月6日23时30分讯(首席记者 黄宇 记者 王玮)“抗疫”好消息频传!2月6日,9名新型冠状病毒感染的肺炎确诊患者分别在重庆三峡中心医院和重庆市公共卫生医疗救治中心治愈出院。这是截至目前重庆治愈出院病人最多的一天,重庆的治愈病例也因此累计达到24例。治愈
查看详情>>
阅读:7.4万回复:100
我亚历山大,保守估计要损失50万
1个月前 收录

管管~~顶上去,拉个头版~~管管~~顶上去,拉个头版~~管管~~顶上去,拉个头版~~如题哈~~反正没得事情做的,大家一起来摆下龙门阵,说说这次疫情对大家的影响或大家的看法我先说我自己吧!对于我来说,压力山大,都开始有想放弃的想法。2019年上半年几乎没赚钱,平过,打走了开支。下
查看详情>>
阅读:12.1万回复:289
再不上班,我就要和我妈打起来了
1个月前 收录

春节回家的年轻人,想和父母和平地度过七天假期,几乎是不可能的。 而新型肺炎疫情的蔓延,假期的延长,更是给家里撒上了火药,一点就能炸。比如前些天,几乎所有家庭都爆发了一场艰难而激烈的拉锯战――到底要不要戴口罩。 好不容易苦口婆心劝住了父母戴口罩,父母又听信了传闻,
查看详情>>
阅读:4.5万回复:84
轨道车站贴标志,消毒情况一目了然
1个月前 收录

2月6日,重庆轨道集团发布消息,为持续做好疫情防控工作,轨道集团在所有消毒后的车站、车厢等公共区域张贴已消毒标志,明确并及时更新消毒日期。消毒
查看详情>>
阅读:1911回复:2
重庆本地感染病例处于上升期
1个月前 收录

夏沛通报有关情况。华龙网-新重庆客户端记者 李裕锟 摄华龙网-新重庆客户端讯(首席记者 佘振芳 记者 伊永军)6日下午,重庆市新型冠状病毒感染的肺炎
查看详情>>
阅读:1.3万回复:33
怀疑自己感染冠状肺炎,去做了检查
1个月前 收录

之前耳朵疼以为自己要聋了,去检查,就是外耳炎这次睡觉起来感觉忽冷忽热,以为自己有症状了,立马去了医院做排查,当然,结果是没有感染,还损失一管血+几大百块钱我TM都想锤自己,总是觉得自己有病……我这是不是真有病啊? 有多少人跟我一样以为自己感染了去医院检查了的?还有
查看详情>>
阅读:13.1万回复:176
在麦德龙看到把包装袋穿身上的朋友
1个月前 收录

今天去麦德龙大采购,停车场停满了车,但商场里人还不算多,除了速冻速食类食品、烘焙食品卖断货之外,其他商品基本上供应充足。当然,入场时需要测体温,人人戴口罩。比较让我忍俊不禁的是一位小伙子,他全程身穿巴宝莉包装袋、头套塑料袋,怡然自得。想起昨天在机场,也看到很多穿一次性雨衣、头套塑料袋、或者眼睛上裹着保鲜膜的旅客。大家都有很强的保护意识了吧
查看详情>>
阅读:2.1万回复:30
渝北一小区封闭管理,半夜发出了…
1个月前 收录

最近笑得最真心的一次,哈哈哈哈!昨天重庆渝北一小区封闭管理,值班大哥广播通知后忘记关话筒,睡着了……昨晚,整个小区都笼罩在恐怖中
查看详情>>
阅读:1.1万回复:12
扫码查询身边疫情!看完有点忐忑
1个月前 收录

微信识别图1二维码,即可查询附近的疫情!前两天天气好,还有人在小区打篮球,结果隔壁小区里确诊一个,再也没有人下楼打篮球了!
查看详情>>
阅读:6.4万回复:101
我们小区开始卖口罩了,2.5一个
1个月前 收录

为小区点赞哈,刚收到消息就下楼去买了。当时就看到几个人拿在手上,实名表扬哈,2.5价格也不贵,为我们小区点赞,杠精就不要来怼了,一家2个已经很不
查看详情>>
阅读:8.6万回复:121
你怎么看突然在朋友圈卖口罩的微商
1个月前 收录

可能不光是我,应该每个人朋友圈里最近都冒出了很多卖口罩的。他们平常可能是代购,可能是卖水果的,也可能是卖三无的……反正部分人不约而同的开始卖
查看详情>>
阅读:4.5万回复:102